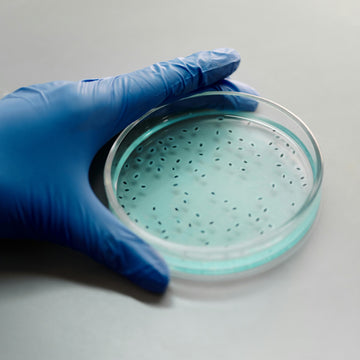

The Science Behind the Protection
Most respiratory viruses enter your body through the nose, where they can quickly attach and start to multiply. VIRALEZE™ provides a protective layer in the nose to help trap and block viruses before they can take hold.
VIRALEZE™ Forms a Barrier
VIRALEZE™ creates an invisible barrier that serves as an extra line of defence against respiratory viruses in the nose, the main point of entry.
VIRALEZE™ Traps & Blocks
The protective moisture barrier traps viruses on contact, blocking their ability to attach to the nasal lining and spread further.
Viruses Clear Away Naturally
Once the virus particles are trapped, they are eliminated from the body naturally via the nasal mucus.
Your first line of defence against colds and respiratory viruses.
VIRALEZE™ works by blocking the interaction between the viral “spike” proteins and the human cells the virus is seeking to infect.


In laboratory studies, astodrimer sodium has been shown to trap and block >99.9% of SARS-CoV-2 within one minute.
Paull, J.R.A. et al. Virucidal and antiviral activity of astodrimer sodium against SARS-CoV-2 in vitro. Antiviral Research 2021, 191, 105089. https://doi.org/10.1016/j.antiviral.2021.105089
From the Research
Astodrimer sodium has been shown to trap and block a broad spectrum of respiratory viruses in laboratory studies, including:
Astodrimer sodium shows significant blocking of virus infection in both pre- and post-infection assays.
Image shows: Dose-response analysis of astodrimer sodium’s ability to block SARS-CoV-2 in Vero E6 cells as measured by infectious virus release. Astodrimer sodium was added to cell cultures 1 hour prior to or 1-hour post-infection.
Paull, J.R.A; Heery, G.P.; Bobardt. M.D.; Castellarnau, A.; Luscombe, A.; Fairley, J.K.; Gallay, P.A., 2021. Virucidal and antiviral activity of astodrimer sodium against SARS-CoV-2 in vitro. Antiviral Research, 191, 105089. https://doi.org/10.1016/j.antiviral.2021.105089


Effect of astodrimer sodium against SARS-CoV-2 measured by a reduction in mean infectious virus compared with virus control (virus without astodrimer sodium) in Vero E6 cells.
Paull, J.R.A; Heery, G.P.; Bobardt. M.D.; Castellarnau, A.; Luscombe, A.; Fairley, J.K.; Gallay, P.A., 2021. Virucidal and antiviral activity of astodrimer sodium against SARS-CoV-2 in vitro. Antiviral Research, 191, 105089. https://doi.org/10.1016/j.antiviral.2021.105089

The Power Behind The Protection
Astodrimer sodium forms an invisible barrier in the nose. It works by physically trapping and blocking respiratory virus particles in the nose, reducing viral load and increasing the rate of viral clearance.
